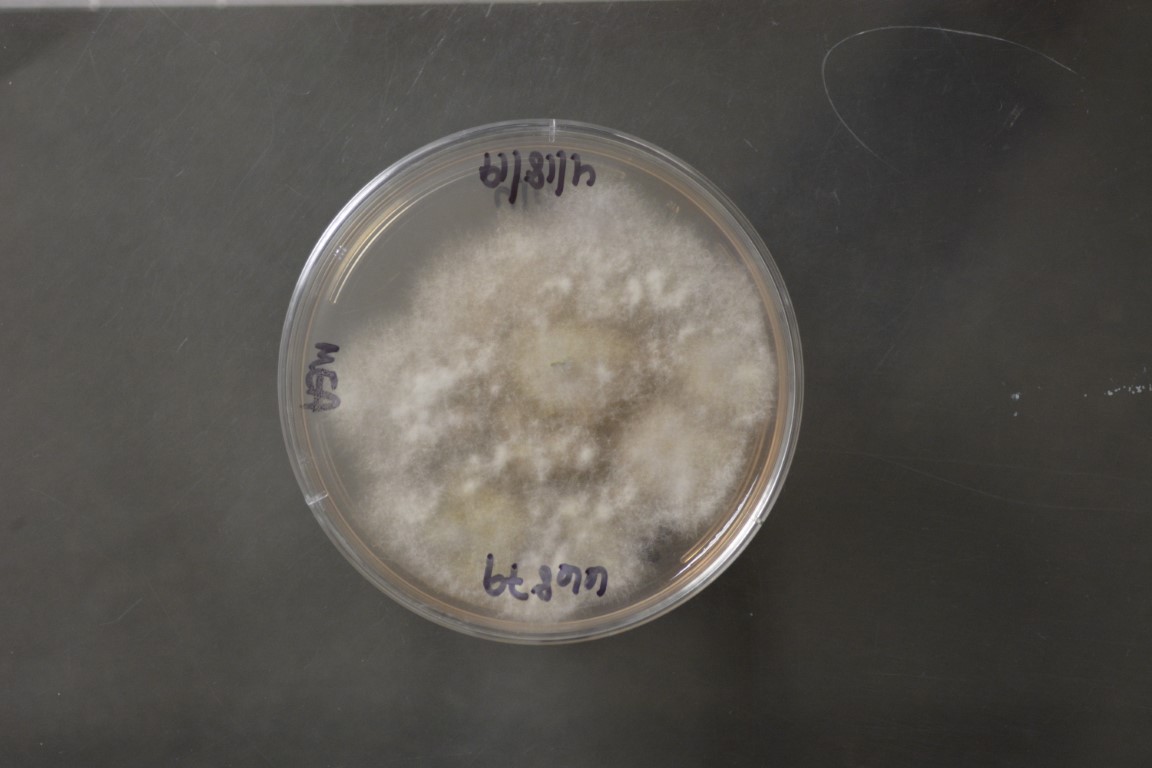

Annulohypoxylon truncatum
NRRL 66879
Accession numbers in other collections:DSM 107925=STMA 16230
Source:Eric Kuhnert;Leibniz University Hannover,Institute for Organic Chemistry,Germany
Isolated from(substrate):Stromata found on unknown dead hardwood
Substrate location:Houston Arboretum,Houston,Harris County,Texas,USA
Growth media:Malt Extract Agar(number 5)
Optimum growth temperature:25C
Strain images:
NRRL_66879_5.JPG

NRRL66879